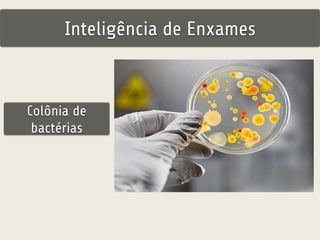
Inteligência de Enxames 
Colônia de 
bactérias

O documento discute inteligência de enxames e algoritmos inspirados nela, como PSO e AFSA. Apresenta os princípios da inteligência de enxames na natureza e como esses algoritmos funcionam, descrevendo em detalhes os comportamentos e mecânicas do PSO e do AFSA para solução de problemas de otimização.



![Inteligência de Enxames
“Inteligência de enxames é uma
propriedade de sistemas de agentes
não-inteligentes de capacidade
individual limitada exibir
comportamento coletivo inteligente” [1]](https://image.slidesharecdn.com/ic-enxamescardumepsoafsa-141121180846-conversion-gate02/85/Inteligencia-de-enxames-Cardume-PSO-AFSA-4-320.jpg)

![Inteligência de Enxames
5 Princípios básicos (Millonas, 1994): [3]
• Proximidade – agentes devem ser capazes de interagir;
• Qualidade – agentes devem ser capazes de avaliar seus
comportamentos;
• Diversidade – permite ao sistema reagir a situações
inesperadas;
• Estabilidade – nem todas as variações ambientais devem
afetar o comportamento de um agente;
• Adaptabilidade – capacidade de adequação a variações
ambientais](https://image.slidesharecdn.com/ic-enxamescardumepsoafsa-141121180846-conversion-gate02/85/Inteligencia-de-enxames-Cardume-PSO-AFSA-9-320.jpg)



![PSO (Particle Swarm Optimization)
“Pelo menos em teoria, membros individuais de um cardume podem
se beneficiar das descobertas e experiências anteriores de outros
membros do cardume na busca por alimentos.
Essa vantagem pode se tornar decisiva, compensando as
desvantagens da competição por alimentos”
Edward Osbourne Wilson (entomologista e biólogo americano) [5]](https://image.slidesharecdn.com/ic-enxamescardumepsoafsa-141121180846-conversion-gate02/85/Inteligencia-de-enxames-Cardume-PSO-AFSA-13-320.jpg)





![PSO (Particle Swarm Optimization)
Objetivo
Encontrar uma solução no universo de
possíveis soluções para um problema de
otimização [6]
Cardume de peixes buscando alimento ou
bando de pássaros buscando abrigo](https://image.slidesharecdn.com/ic-enxamescardumepsoafsa-141121180846-conversion-gate02/85/Inteligencia-de-enxames-Cardume-PSO-AFSA-19-320.jpg)
![PSO (Particle Swarm Optimization)
Exemplo (1) [5]](https://image.slidesharecdn.com/ic-enxamescardumepsoafsa-141121180846-conversion-gate02/85/Inteligencia-de-enxames-Cardume-PSO-AFSA-20-320.jpg)
![PSO (Particle Swarm Optimization)
Exemplo (2) [5]](https://image.slidesharecdn.com/ic-enxamescardumepsoafsa-141121180846-conversion-gate02/85/Inteligencia-de-enxames-Cardume-PSO-AFSA-21-320.jpg)
![PSO (Particle Swarm Optimization)
Função Schwefel [5]](https://image.slidesharecdn.com/ic-enxamescardumepsoafsa-141121180846-conversion-gate02/85/Inteligencia-de-enxames-Cardume-PSO-AFSA-22-320.jpg)
![PSO (Particle Swarm Optimization)
Função Schwefel [5]](https://image.slidesharecdn.com/ic-enxamescardumepsoafsa-141121180846-conversion-gate02/85/Inteligencia-de-enxames-Cardume-PSO-AFSA-23-320.jpg)
![PSO (Particle Swarm Optimization)
Função Schwefel [5]](https://image.slidesharecdn.com/ic-enxamescardumepsoafsa-141121180846-conversion-gate02/85/Inteligencia-de-enxames-Cardume-PSO-AFSA-24-320.jpg)
![PSO (Particle Swarm Optimization)
Função Schwefel [5]](https://image.slidesharecdn.com/ic-enxamescardumepsoafsa-141121180846-conversion-gate02/85/Inteligencia-de-enxames-Cardume-PSO-AFSA-25-320.jpg)



![PSO (Particle Swarm Optimization)
Conceitos
vi(t+1) = ω×vi(t) + ϕ1 (pi−xi(t)) +
ϕ2×(pl−xi(t))
Aceleração
cognitiva
Aceleração
social
ω (<1) = peso de inércia
(grande: exploração global;
pequeno: exploração local)
Φ1 = c1 * rand(); Φ2 = c2 * Rand()
rand() e Rand(): funções randômicas uniformemente
distribuídas entre [0,1]
c1 e c2: constantes de aceleração de aprendizado, tal que
c1 + c2 = 4.1 e geralmente c1 = c2 = 2.05](https://image.slidesharecdn.com/ic-enxamescardumepsoafsa-141121180846-conversion-gate02/85/Inteligencia-de-enxames-Cardume-PSO-AFSA-29-320.jpg)
![PSO (Particle Swarm Optimization)
Pseudo-código
[7]](https://image.slidesharecdn.com/ic-enxamescardumepsoafsa-141121180846-conversion-gate02/85/Inteligencia-de-enxames-Cardume-PSO-AFSA-30-320.jpg)

![PSO (Particle Swarm Optimization)
Outros parâmetros
Número de partículas: geralmente entre 20 e 40,
sendo 10 suficiente muitas vezes [8];
Condição de encerramento do algoritmo:
número de iterações, solução ótima, margem de
erro mínimo;](https://image.slidesharecdn.com/ic-enxamescardumepsoafsa-141121180846-conversion-gate02/85/Inteligencia-de-enxames-Cardume-PSO-AFSA-32-320.jpg)


![PSO (Particle Swarm Optimization)
PSO Local x Global (topologias)
[5]
Exemplo de PSO local e definição das
Vizinhanças [9]](https://image.slidesharecdn.com/ic-enxamescardumepsoafsa-141121180846-conversion-gate02/85/Inteligencia-de-enxames-Cardume-PSO-AFSA-35-320.jpg)




![Artificial Fish Swarm Algorithm
X: posição do AF
(Artificial Fish)
X = [x1, x2, ...., xn]](https://image.slidesharecdn.com/ic-enxamescardumepsoafsa-141121180846-conversion-gate02/85/Inteligencia-de-enxames-Cardume-PSO-AFSA-40-320.jpg)

![Artificial Fish Swarm Algorithm
xv: nova posição
preterida, dentro da
visão
xv = [xv1,xv2, ..., xvn]](https://image.slidesharecdn.com/ic-enxamescardumepsoafsa-141121180846-conversion-gate02/85/Inteligencia-de-enxames-Cardume-PSO-AFSA-42-320.jpg)




















![Artificial Fish Swarm Algorithm
Modificações & Resultados
[1] HAP (híbrido de PSO e AFSA), para treinamento
de redes neurais feedforward
Função:
t = sin(π × p)](https://image.slidesharecdn.com/ic-enxamescardumepsoafsa-141121180846-conversion-gate02/85/Inteligencia-de-enxames-Cardume-PSO-AFSA-63-320.jpg)

![Artificial Fish Swarm Algorithm
Modificações & Resultados
[2] Problema do Caixeiro Viajante, comparando os
algoritmos:
AS – Ant System
DPSO – Discrete PSO
AFSA – AFSA1 (δ fixo) e AFSA2 (δ adaptativo)
δ adaptativo usado: δ diminui 20% a cada 25
iterações sem mudança no melhor fitness
encontrado pelo cardume](https://image.slidesharecdn.com/ic-enxamescardumepsoafsa-141121180846-conversion-gate02/85/Inteligencia-de-enxames-Cardume-PSO-AFSA-65-320.jpg)


![Artificial Fish Swarm Algorithm
Modificações & Resultados
[3] Problema de Alocação de Ancoradouro (Berth
allocation problem)](https://image.slidesharecdn.com/ic-enxamescardumepsoafsa-141121180846-conversion-gate02/85/Inteligencia-de-enxames-Cardume-PSO-AFSA-68-320.jpg)






![Artificial Fish Swarm Algorithm
Há muitas outras modificações, híbridos, etc.:
• mAFS – Modified AFS [4]
• mAFS-P – Modified AFS Priority-based [4]
• MAFSA – Modified AFSA {5]
• Fuzzy Adaptive Artificial Fish Swarm Algorithm [6]
E até uma abordagem criada na UPE (Universidade de
Pernambuco):
• FSS - Fish School Search [7]](https://image.slidesharecdn.com/ic-enxamescardumepsoafsa-141121180846-conversion-gate02/85/Inteligencia-de-enxames-Cardume-PSO-AFSA-75-320.jpg)
![Bibliografia e referências
[1] http://www.fabriciobreve.com/material/compavancada/CA-Aula8-
InteligenciaDeEnxames.pdf
[2] ftp://ftp.dca.fee.unicamp.br/pub/docs/vonzuben/ia013_1s07/topico4_07.pdf
[3] http://www.scielo.br/pdf/ca/v20n3/02.pdf
[4] Eberhart, R. C. & Kennedy, J. (2001). Swarm Intelligence
[5] http://www.dep.uminho.pt/EscolaEAs/palestras/Inteligencia%20de%20enxames%20-
%20P2%20PSO%20-%20UFMG%20-%2023_10_2009%20P&B.pdf
[6] http://wiki.icmc.usp.br/images/e/eb/Aula_4_CB_Enxames_PSO.pdf
[7] http://www.fabriciobreve.com/material/compavancada/CA-Aula9-
InteligenciaDeEnxamesP2.pdf
[8] http://www.swarmintelligence.org/tutorials.php
[9] http://web.ist.utl.pt/gdgp/VA/pso.htm](https://image.slidesharecdn.com/ic-enxamescardumepsoafsa-141121180846-conversion-gate02/85/Inteligencia-de-enxames-Cardume-PSO-AFSA-76-320.jpg)
![Bibliografia e referências
[10] Ben Niu , Li Li, A Hybrid Particle Swarm Optimization for Feed-Forward Neural Network
Training, Proceedings of the 4th international conference on Intelligent Computing:
Advanced Intelligent Computing Theories and Applications - with Aspects of Artificial
Intelligence, September 15-18, 2008, Shanghai, China [2]
[11]
http://www.infoteca.inf.br/contecsi/smarty/templates/arquivos_template/upload_arquivos/
acervo/docs/PDFs/068.pdf
[12] http://www.mecs-press.org/ijisa/ijisa-v2-n1/IJISA-V2-N1-6.pdf
[13] http://repositorium.sdum.uminho.pt/bitstream/1822/14478/1/AFSmodified_ICCSA.pd
f
[14] http://www.ijcte.org/papers/003.pdf
[15] http://ceit.aut.ac.ir/~meybodi/paper/yazdani-Springer-Fuzzy-Fish%20Swarm-2010.pdf
[16] http://www.fbln.pro.br/fss/](https://image.slidesharecdn.com/ic-enxamescardumepsoafsa-141121180846-conversion-gate02/85/Inteligencia-de-enxames-Cardume-PSO-AFSA-77-320.jpg)